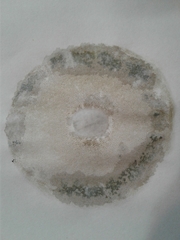
Gyroporus castaneus

Gyroporus castaneus: taxon details and analytics
- Domain
- Kingdom
- Fungi
- Phylum
- Basidiomycota
- Class
- Agaricomycetes
- Order
- Boletales
- Family
- Gyroporaceae
- Genus
- Gyroporus
- Species
- Gyroporus castaneus
- Scientific Name
- Gyroporus castaneus
Summary description from Wikipedia:
Gyroporus castaneus
Gyroporus castaneus, commonly known as the chestnut bolete, is a small, white-pored mushroom in the Gyroporaceae of order Boletales. It has a brown cap, and is usually found with oak trees. It differs from the true boletes in that the spores are a pale straw colour.
...Gyroporus castaneus in languages:
- Bokmål
- kastanjerørsopp
- Czech
- hřibník kaštanový
- Danish
- Kastanie-kammerrørhat
- Dutch
- Kaneelboleet
- English
- Chestnut Bolete
- Finnish
- kastanjatatti
- French
- Bolet châtain
- German
- Hasenröhrling
- Hebrew
- חרירית ערמונית
- Hebrew
- חֲרִירִית עַרְמוֹנִית
- Hungarian
- Gesztenyebarna üregestinóru
- Japanese
- クリイロイグチ
- Lithuanian
- Smiltyninis Šilbaravykis
- Polish
- piaskowiec kasztanowaty
- Russian
- Гиропор каштановый
- Swedish
- kastanjesopp
Images from inaturalist.org observations:
We recommend you sign up for this excellent, free service.
Parent Taxon
Sibling Taxa
- Gyroporus australiensis
- Gyroporus borealis
- Gyroporus brunnescens
- Gyroporus castaneus
- Gyroporus cyanescens
- Gyroporus furvescens
- Gyroporus lacteus
- Gyroporus mcnabbii
- Gyroporus naranjus
- Gyroporus occidentalis
- Gyroporus paralongicystidiatus
- Gyroporus phaeocyanescens
- Gyroporus pseudocyanescens
- Gyroporus pseudolacteus
- Gyroporus punctatus
- Gyroporus purpurinus
- Gyroporus robinsonii
- Gyroporus roseialbus
- Gyroporus smithii
- Gyroporus subalbellus
- Gyroporus umbrinisquamosus
Top Observation Places
- Providence
- Peabody
- South Peabody
- Nashua
- Skokie
- The Bronx
- Yonkers
- Washington Heights
- Astoria
- Harlem
- East Harlem
- Elmhurst
- Corona
- Fordham
- Kings Bridge
- Mount Vernon
- Forest Hills
- Jackson Heights
- Parkchester
- Wakefield
- Mott Haven
- Brooklyn
- Flatbush
- Flatlands
- Cambridge
- Newton
- Somerville
- Waltham
- Brookline
- Medford
- Washington
- Arlington
- Alexandria
- Silver Spring
- Rockville
- Bethesda
- Reston